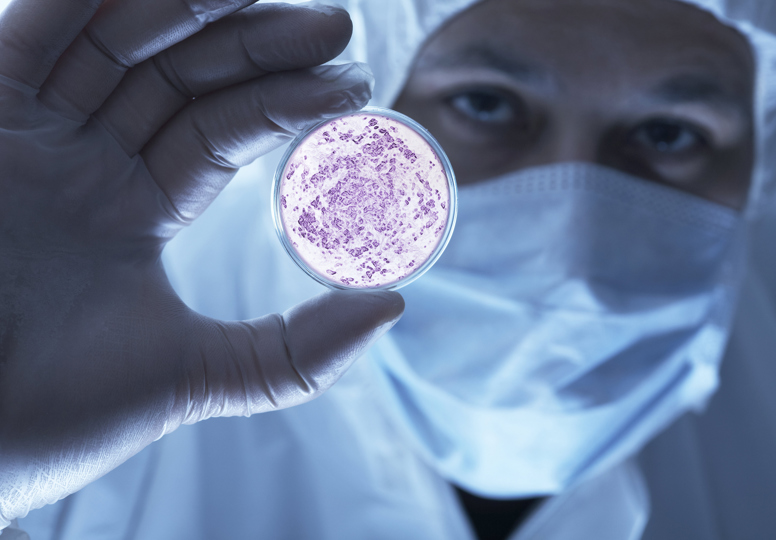

Work
Keeping specialists up-to-date on EU research
European Commission
Welcome to Tipik, a one-stop shop for all your communication needs. We craft communication strategies that help you reach the people that matter most. Our international team has all angles covered: from conception to roll-out online and in print. Digital is our first love, but not our only love. Trust us with your communications and events and we’ll design and implement a cost-effective results-based approach for you. Take a look, our work speaks for itself.
10 podcasts
550 articles
600 scientists
and innovators interviewed
1000+ social media posts
446animations for social
26 paid
multilingual
campaigns
Across Google, Facebook, Instagram, X, LinkedIn and YouTube.
50 press releases
in 24 languages
10 media
partnerships
8500 journalists reached
Topics we are
talking
about
100 events
In20 + countries
inside and
outside the EU
3 - 4 events
per week
in peak season
30000 participants
welcomed onsite and online
3317 participants
for biggest event
10 participants
for smallest event
39 websites
for campaigns and events
Drupal/Umbraco/Wordpress/PHP/C#/Java
Fully accessible sites and own event platform.
Saved on servers in Europe.
46% reduction
in carbon
emissions
Generated through our use of servers
25 languages
56people
34 women
22 men
Management
60% women
40% men
40Average age
14 nationalities
90% from the EU
10% from beyond
10 languages
And we all speak English!
8 new employees
*** Ecodynamic Enterprise